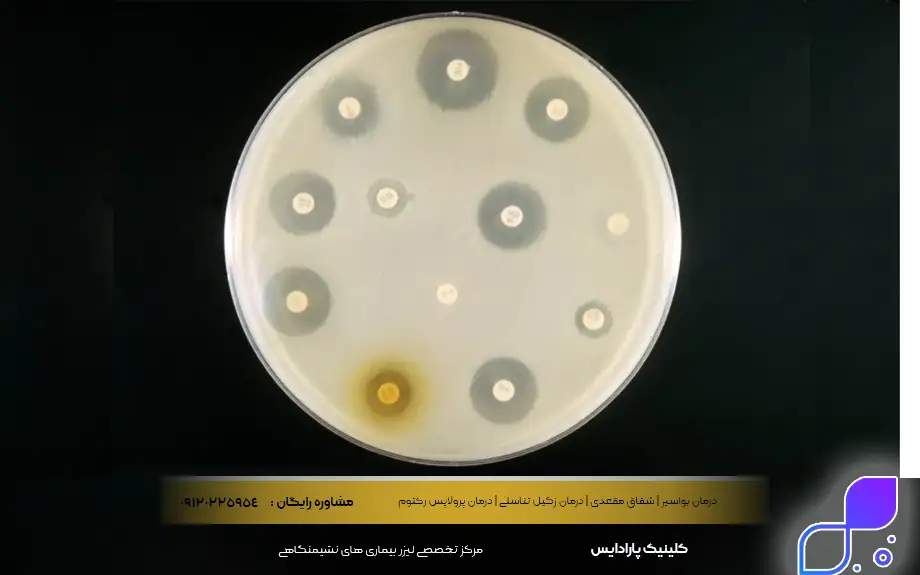
قرص آنتی بیوتیک

زمانی که علائم بیماریهایی مانند گلودرد شدید، تب طولانی یا عفونتهای پوستی به سراغمان میآید، اولین چیزی که اغلب به ذهنمان میرسد استفاده از آنتی بیوتیک یا همان اصطلاح رایج میان مردم، یعنی چرک خشک کن است. بسیاری از ما تصور میکنیم که هر نوع ناخوشی و دردی با مصرف یک دوره قرص چرک خشک کن برطرف میشود، اما واقعیت پزشکی کمی پیچیدهتر است. مصرف خودسرانه این داروها بدون دانستن منشأ بیماری، نه تنها کمکی به بهبود نمیکند، بلکه میتواند بدن را در برابر باکتریهای مقاوم، خلع سلاح کند. بنابراین، شناخت صحیح زمان و نحوه مصرف این داروها برای حفظ سلامتی حیاتی است.
در برخی موارد، عفونتها پیچیدهتر هستند و نواحی خاصی از بدن مانند ناحیه مقعدی (نشیمنگاه) را درگیر میکنند که نیازمند تخصص ویژه است. در چنین شرایطی، مراجعه به مراکز تخصصی مانند کلینیک پارادایس که به عنوان مرکز معتبر درمان بیماری های نشیمنگاهی در تهران شناخته میشود، بهترین راهکار است. متخصصان در این مرکز با تشخیص دقیق نوع عفونت، بهترین روش درمانی و در صورت نیاز، مناسبترین کپسول چرک خشک کن یا روشهای جراحی نوین را تجویز میکنند تا روند درمان بدون بازگشت و با کمترین عارضه طی شود.
آنتی بیوتیک چیست و انواع آن
آنتی بیوتیک چیست و انواع آن سوالی است که پاسخ به آن، مرز بین درمان درست و آسیب به بدن را مشخص میکند. به زبان ساده، آنتیبیوتیکها داروهایی قدرتمند هستند که منحصراً برای مبارزه با عفونتهای ناشی از باکتریها طراحی شدهاند و بر روی بیماریهای ویروسی (مثل سرماخوردگی یا آنفولانزا) هیچ اثری ندارند. این داروها یا باکتریها را مستقیماً میکشند (باکتریکش) و یا جلوی رشد و تکثیر آنها را میگیرند (باکتریواستاتیک) تا سیستم ایمنی بدن بتواند راحتتر با عامل بیماریزا مبارزه کند.
تنوع این داروها بسیار زیاد است و هر کدام برای دسته خاصی از باکتریها ساخته شدهاند؛ به همین دلیل است که هرگز نباید قرص چرک خشک کن باقیمانده از بیماری قبلی را برای بیماری جدید مصرف کرد. پزشکان بر اساس طیف اثرگذاری، این داروها را به دستههای مختلفی تقسیم میکنند که شناخت آنها به درک بهتر روند درمان کمک میکند.
انواع رایج آنتیبیوتیکها عبارتند از:
- پنیسیلینها (Penicillins): مانند آموکسیسیلین (معروفترین چرک خشک کن برای عفونتهای عمومی).
- سفالوسپورینها (Cephalosporins): مانند سفالکسین (اغلب برای عفونتهای پوستی و بافت نرم).
- ماکرولیدها (Macrolides): مانند آزیترومایسین (کاربردی برای عفونتهای تنفسی).
- فلوروکینولونها (Fluoroquinolones): مانند سیپروفلوکساسین (معمولاً برای عفونتهای ادراری شدید).
- تتراسایکلینها (Tetracyclines): مانند داکسیسایکلین (برای جوشهای صورت و برخی عفونتهای خاص).
- آمینوگلیکوزیدها (Aminoglycosides): دستهای قوی که معمولاً تزریقی هستند و در بیمارستان استفاده میشوند.
مرکز کنترل و پیشگیری از بیماری Centers for Disease Control and Prevention (CDC) که یکی از آژانسهای ایالات متحده آمریکا و تحت نظر وزارت بهداشت است در مورد زمان استفاده از انتی بیوتیک چنین بیان می کند:
آنتیبیوتیکها تنها زمانی باید مصرف شوند که عفونت باکتریایی قطعی باشد؛ آنها روی ویروسها مؤثر نیستند، و مصرف بیمورد میتواند بیفایده و مضر باشد.

قرص آنتی بیوتیک برای چیست
بسیاری از مراجعین میپرسند که قرص آنتی بیوتیک برای چیست و آیا برای هر نوع دردی کاربرد دارد؟ پاسخ صریح و علمی این است که این قرصها فقط و فقط برای از بین بردن عفونتهای باکتریایی فعال در بدن تجویز میشوند. مکانیسم اثر آنها به گونهای است که به دیواره سلولی یا ساختار داخلی باکتری حمله کرده و آن را نابود میکنند. در بیماریهای ویروسی (مثل این موارد: کرونا، آنفولانزا یا سرماخوردگی معمولی) مصرف قرص چرک خشک کن نه تنها بیفایده است، بلکه با از بین بردن باکتریهای مفید روده و ایجاد مقاومت دارویی، بدن شما را ضعیفتر میکند.
بنابراین، پزشک تنها زمانی اقدام به تجویز کپسول چرک خشک کن میکند که علائم بالینی و آزمایشگاهی، وجود باکتری را تایید کنند. هدف اصلی، پاکسازی بدن از میکروبهای مضر، جلوگیری از گسترش عفونت به خون (سپتیسمی) و کاهش التهاب ناشی از فعالیت باکتریهاست.
کاربردهای اصلی آنتیبیوتیکها شامل موارد زیر است:
- عفونتهای گلو و لوزهها: مانند فارنژیت استرپتوکوکی (گلو درد چرکی).
- عفونتهای دستگاه ادراری (UTI): عفونت مثانه و کلیه.
- عفونتهای پوستی: مانند سلولیت یا عفونتهای پس از زخم و جراحی.
- عفونتهای دندانی: آبسه و عفونت لثه.
- عفونتهای گوش میانی: به خصوص در کودکان.
- سینه پهلو (پنومونی): عفونتهای شدید ریوی با منشأ باکتری.
- بیماریهای مقاربتی باکتریایی: مانند سوزاک و کلامیدیا.
تشخیص عفونت نیازمند آنتیبیوتیک
یکی از چالشهای اصلی در پزشکی این است که تشخیص عفونت نیازمند آنتیبیوتیک چگونه است و پزشک چطور متوجه میشود بیمار به این دارو نیاز دارد یا خیر. برخلاف باور عموم، رنگ ترشحات بینی (سبز یا زرد بودن) به تنهایی دلیل قطعی برای مصرف آنتی بیوتیک نیست. پزشکان برای این تشخیص، مجموعهای از علائم بالینی مثل تب بالا، طول مدت بیماری، شدت درد و معاینه فیزیکی دقیق را در نظر میگیرند. فرآیند تشخیص عفونت های نیازمند آنتیبیوتیک، فراتر از یک نگاه ساده است و نیازمند بررسی دقیق برای تفکیک عفونت ویروسی از باکتریایی میباشد تا از تجویز بیرویهی دارو جلوگیری شود.
در موارد پیچیدهتر یا زمانی که عفونت به درمانهای اولیه پاسخ نمیدهد، پزشک به علائم ظاهری اکتفا نمیکند و سراغ روشهای آزمایشگاهی میرود. این کار باعث میشود تا دقیقاً نوع باکتری و داروی موثر بر آن شناسایی شود (تست حساسیت آنتیبیوتیکی) و از مصرف داروی اشتباه جلوگیری گردد.
روشهای تشخیص توسط پزشک شامل موارد زیر است:
- معاینه بالینی دقیق: بررسی تورم گرههای لنفاوی، صدای ریه و وضعیت گلو.
- آزمایش خون (CBC): بررسی شمارش گلبولهای سفید (افزایش آنها نشانه عفونت باکتریایی است).
- کشت ادرار یا مخاط: نمونهبرداری از گلو، ادرار یا زخم برای رشد دادن باکتری در آزمایشگاه.
- تست آنتیبیوگرام: آزمایشی که نشان میدهد باکتری مورد نظر به کدام چرک خشک کن حساس است و کدام دارو روی آن اثر ندارد.
- تصویربرداری: مانند عکس رادیولوژی قفسه سینه برای تشخیص ذاتالریه.
نحوه صحیح مصرف آنتی بیوتیکها
رعایت نحوه صحیح مصرف آنتی بیوتیکها یکی از مهمترین اصول در درمان عفونتهای باکتریایی است، زیرا مصرف نامنظم یا قطع زودهنگام دارو میتواند باعث بازگشت شدیدتر بیماری شود. بسیاری از افراد تصور میکنند که با شروع مصرف دارو و بهتر شدن علائم در دو یا سه روز اول، میتوانند درمان را متوقف کنند؛ اما این بزرگترین اشتباه است. آنتیبیوتیک باید دقیقاً سر ساعت مشخص شده مصرف شود (مثلاً هر ۸ ساعت یا هر ۱۲ ساعت) تا سطح دارو در خون ثابت بماند و فرصتی به باکتریها برای تکثیر مجدد داده نشود.
نکته کلیدی دیگر در مورد نحوه صحیح مصرف قرص چرک خشک کن، توجه به دستورات خاص هر دارو است؛ برخی باید با معده خالی و برخی با معده پر مصرف شوند تا جذب بهتری داشته باشند. همچنین نوشیدن آب کافی همراه با کپسول به حل شدن و جذب بهتر آن کمک کرده و از آسیب به مری و معده جلوگیری میکند. فراموش نکنید که دوزهای فراموش شده را نباید با دو برابر کردن وعده بعدی جبران کرد، بلکه باید طبق دستور پزشک عمل نمود.
«استفاده از انتی بیوتیک حتماً باید تحت نظر پزشک باشد و دوز و زمانبندی آن دقیق رعایت شود تا فرد دچار عوارض ناخواسته نشده و درمان به صورت کامل انجام گیرد.»
نکات کلیدی در نحوه مصرف:
- ساعت دقیق: تنظیم زنگ هشدار برای مصرف سر وقت دارو (تداخل نداشتن با ساعت خواب).
- تکمیل دوره درمان: مصرف دارو تا آخرین دانه، حتی اگر احساس بهبودی کامل دارید.
- همراه با آب: بلعیدن قرص با یک لیوان کامل آب (نه چای، شیر یا آبمیوه مگر با دستور پزشک).
- تداخل با غذا: بررسی بروشور دارو برای مصرف قبل یا بعد از غذا.
- عدم خرد کردن قرص: کپسولها و قرصهای روکشدار را نباید جوید یا باز کرد.
عوارض آنتیبیوتیکها
هر داروی شیمیایی در کنار فواید درمانی، ممکن است اثرات ناخواستهای نیز داشته باشد و شناخت عوارض آنتیبیوتیکها به بیمار کمک میکند تا در صورت بروز علائم غیرعادی، سریعاً واکنش مناسب نشان دهد. شایعترین مشکلی که مصرفکنندگان با آن مواجه میشوند، مشکلات گوارشی است؛ زیرا چرک خشک کنها قادر به تفکیک باکتریهای خوب و بد نیستند و با از بین بردن فلور طبیعی روده (باکتریهای مفید)، باعث دل پیچه، نفخ یا اسهال میشوند. این موضوع نشان میدهد که دارو در حال اثرگذاری است اما تعادل بدن را نیز تحت تاثیر قرار داده است.
علاوه بر مشکلات گوارشی، واکنشهای آلرژیک نیز بخش مهمی از عوارض کپسول چرک خشک کن محسوب میشوند که میتوانند از یک خارش پوستی ساده تا تنگی نفس شدید (آنافیلاکسی) متغیر باشند. همچنین در خانمها، مصرف طولانیمدت این داروها ممکن است زمینه را برای عفونتهای قارچی واژینال فراهم کند، زیرا باکتریهای محافظ از بین رفتهاند. آگاهی از این عوارض باعث میشود بیمار نترسد، اما در صورت شدت گرفتن علائم حتماً با پزشک مشورت کند.
عوارض جانبی قرص چرک خشک کن عبارتند از:
- مشکلات گوارشی: تهوع، استفراغ، اسهال و درد معده.
- عفونتهای قارچی: برفک دهان یا عفونت واژینال در خانمها.
- واکنشهای حساسیتی: بثورات پوستی (راش)، خارش و کهیر.
- حساسیت به نور: برخی آنتیبیوتیکها (مثل داکسیسایکلین) پوست را در برابر آفتاب حساس میکنند.
- تغییر رنگ دندان: در کودکان (به خصوص با مصرف تتراسایکلین).
Fairfax County Health Department دفتر بهداشت عمومی فیرفکس کانتی، در راهنمای محدود کردن مصرف غیرضروری کپسول های چرک خشک کن چنین می گوید:
مصرف خودسرانه یا زودهنگام آنتیبیوتیکها نه تنها کمکی نمیکند، بلکه ممکن است منجر به مقاومت میکروبی، نارسایی کلیه یا سایر عوارض شود.

موارد منع مصرف و احتیاط قرص چرک خشک کن
پیش از تجویز هر نسخهای، پزشک باید تاریخچه پزشکی بیمار را بررسی کند، زیرا موارد منع مصرف و احتیاط قرص چرک خشک کن در استفاده از آنتیبیوتیکها بسیار حیاتی است و نادیده گرفتن آن میتواند خطرات جانی به همراه داشته باشد. برای مثال، افرادی که سابقه حساسیت شدید به پنیسیلین دارند، نباید داروهای خانواده پنیسیلین یا حتی برخی سفالوسپورینها را مصرف کنند. همچنین وضعیت سلامت کبد و کلیه بیمار تعیینکننده نوع و دوز دارو است؛ چرا که دفع بسیاری از این داروها از طریق کلیه انجام میشود و در صورت نارسایی کلیوی، تجمع دارو در بدن باعث مسمومیت میشود.
دروه بارداری و شیردهی نیز از مهمترین زمانهایی است که باید موارد منع مصرف و احتیاط کپسول چرک خشک کن را جدی گرفت. برخی از آنتیبیوتیکها میتوانند از جفت عبور کرده و بر رشد جنین اثر منفی بگذارند یا از طریق شیر مادر به نوزاد منتقل شوند. بنابراین، هیچگاه نباید داروی باقیمانده از قبل را به کودکان، زنان باردار یا سالمندان داد، زیرا فیزیولوژی بدن این افراد حساسیت بالایی دارد و نیازمند دوزبندی دقیق پزشکی است.
لیست موارد احتیاط و منع مصرف:
- سابقه آلرژی: حساسیت قبلی به هر نوع چرک خشک کن (بهویژه پنیسیلین و سولفونامیدها).
- بارداری و شیردهی: ممنوعیت بخاطر عوارض مصرف پماد تتراسایکلین و برخی دیگر از گروهها.
- نارسایی کلیوی و کبدی: نیاز به تنظیم دقیق دوز یا تغییر نوع دارو.
- بیماریهای خاص: مانند فاویسم (حساسیت به باقلا) که با برخی آنتیبیوتیکها تحریک میشود.
- سن بیمار: منع مصرف برخی داروها برای نوزادان یا کودکان زیر ۸ سال (به دلیل اثر بر رشد استخوان و دندان).
تداخلات دارویی آنتی بیوتیکها
یکی از موضوعات پیچیده در داروسازی، تداخلات دارویی آنتی بیوتیکها با سایر داروها و حتی مکملهای غذایی است که میتواند اثر درمانی را خنثی کرده یا عوارض جانبی را تشدید کند. زمانی که دو دارو همزمان مصرف میشوند، ممکن است بر جذب، متابولیسم یا دفع یکدیگر اثر بگذارند. برای مثال، مصرف همزمان برخی آنتیبیوتیکها با داروهای رقیقکننده خون مثل وارفارین، میتواند خطر خونریزی را به شدت افزایش دهد، زیرا باکتریهای رودهای که ویتامین K (موثر در انعقاد خون) تولید میکنند، از بین میروند.
مورد شایع دیگر در بحث تداخلات دارویی کپسول چرک خشک کن، کاهش اثر قرصهای پیشگیری از بارداری است. برخی از چرک خشک کنها مانند ریفامپین میتوانند متابولیسم هورمونها را تسریع کرده و احتمال بارداری ناخواسته را افزایش دهند. همچنین مصرف مکملهای حاوی کلسیم، آهن، منیزیم و روی (زینک) همزمان با برخی آنتیبیوتیکها (مثل تتراسایکلین و سیپروفلوکساسین)، باعث اتصال دارو به فلزات و عدم جذب آن در بدن میشود.
تداخلات مهم قرص چرک خشک کن که باید بدانید:
- داروهای رقیقکننده خون: مثل وارفارین (خطر خونریزی).
- قرصهای ضدبارداری: کاهش اثر پیشگیری و نیاز به روش کمکی.
- داروهای ضداسید معده (آنتیاسید): جلوگیری از جذب آنتیبیوتیک.
- مکملهای ویتامینی و مواد معدنی: کلسیم، آهن و زینک (باید با فاصله زمانی مصرف شوند).
- الکل: ایجاد عوارض شدید گوارشی و عصبی (بهویژه با مترونیدازول).

خطرات مصرف خودسرانه آنتی بیوتیک
امروزه جامعه پزشکی با بحرانی جدی به نام خطرات مصرف خودسرانه آنتی بیوتیک و مقاومت آنتیبیوتیکی روبروست که سازمان بهداشت جهانی (WHO) آن را یکی از ۱۰ تهدید اصلی برای سلامت بشر میداند. زمانی که شما بدون تجویز پزشک برای یک سرماخوردگی ویروسی ساده چرک خشک کن میخورید، یا دوره درمان خود را کامل نمیکنید، باکتریهای ضعیف میمیرند اما باکتریهای قویتر زنده میمانند، تغییر شکل میدهند و یاد میگیرند که چگونه در برابر دارو مقاومت کنند. این باکتریهای جهشیافته (Superbugs) دیگر به داروهای معمولی پاسخ نمیدهند.
نتیجهی ترسناک نادیده گرفتن خطرات مصرف خودسرانه چرک خشک کن این است که در آیندهای نزدیک، عفونتهای سادهای مثل یک زخم کوچک، عفونت ادراری یا ذاتالریه ممکن است غیرقابل درمان شوند و منجر به مرگ بیمار گردند. علاوه بر این، مصرف خودسرانه میتواند علائم اصلی بیماریهای خطرناک (مثل آپاندیسیت یا مننژیت) را پنهان کرده و تشخیص صحیح پزشک را با تاخیر مواجه کند که این خود تهدیدی برای جان بیمار است.
پیامدهای مصرف بدون نسخه و خودسرانه:
- ظهور ابرمیکروبها: ایجاد باکتریهای مقاوم به تمام درمانهای موجود.
- شکست در درمان: طولانی شدن دوره بیماری و عدم بهبودی.
- افزایش هزینهها: نیاز به بستری شدن در بیمارستان و استفاده از داروهای گرانقیمت و تزریقی.
- آسیب به میکروبیوم بدن: نابودی باکتریهای مفید روده و تضعیف سیستم ایمنی دائمی.
- تشخیص اشتباه: پنهان کردن علائم واقعی بیماریهای جدی.
آنتی بیوتیک قوی
در دنیای پزشکی، اصطلاح آنتی بیوتیک قوی معمولاً به داروهایی اطلاق میشود که “طیف اثر گسترده” دارند یا برای درمان باکتریهای مقاوم به درمانهای معمولی به کار میروند. زمانی که عفونت با داروهای خط اول (مثل آموکسیسیلین معمولی) کنترل نمیشود، پزشک ناچار است به سراغ این دسته از داروها برود. این داروها قدرت نفوذ بالایی به بافتها دارند و میتوانند ساختار دفاعی باکتریهای سرسخت را در هم بشکنند.
با این حال، باید توجه داشت که مصرف یک کپسول چرک خشک کن قوی بدون نظارت دقیق پزشک، مثل استفاده از یک سلاح سنگین برای یک هدف کوچک است؛ این کار نه تنها باکتریهای مفید بدن را نابود میکند، بلکه ریسک عوارض جانبی شدید مانند مشکلات گوارشی و آسیب کلیوی را افزایش میدهد. پزشکان این داروها را معمولاً برای عفونتهای بیمارستانی، ذاتالریههای شدید یا عفونتهای پیچیده شکمی تجویز میکنند.
دستههای دارویی با دوزهای قوی و اثرگذاری بالا (صرفاً جهت آگاهی):
- فلوروکینولونها: مانند لووفلوکساسین (برای عفونتهای شدید ریوی و ادراری).
- کارباپنمها: مانند ایمیپنم (معمولاً تزریقی و برای عفونتهای بسیار مقاوم بیمارستانی).
- سفالوسپورینهای نسل سوم و چهارم: مانند سفتریاکسون یا سفپیم.
- وانکومایسین: دارویی بسیار قدرتمند برای عفونتهای استافیلوکوکی مقاوم (MRSA).

عکس قرص چرک خشک کن قوی
بسیاری از کاربران برای اطمینان از دارویی که مصرف میکنند، در اینترنت به دنبال عکس قرص چرک خشک کن قوی میگردند تا شکل ظاهری آن را با داروی خود تطبیق دهند. واقعیت این است که قدرت یک آنتیبیوتیک را نمیتوان از روی ظاهر، رنگ یا اندازه قرص تشخیص داد؛ برخی از قویترین آنتیبیوتیکها قرصهای کوچک و سفیدی هستند، در حالی که برخی مکملهای ویتامین ظاهری بزرگ و رنگی دارند. معمولاً قرصهای دوز بالا (مثل کو-آموکسیکلاو ۶۲۵ یا سیپروفلوکساسین ۵۰۰) ابعاد بزرگتری دارند و در بستهبندیهای محافظتشده (بلیستر) عرضه میشوند تا از رطوبت و نور در امان بمانند.
قوی ترین قرص آنتی بیوتیک برای عفونت واژن
عفونتهای ناحیه تناسلی بانوان میتواند منشأ قارچی، باکتریایی یا انگلی داشته باشد و انتخاب قوی ترین قرص آنتی بیوتیک برای عفونت واژن کاملاً وابسته به تشخیص عامل بیماری است. اگر عفونت از نوع “واژینوز باکتریایی” باشد، استفاده از داروهای ضدقارچ بیفایده است و نیاز به آنتیبیوتیکهای خاصی است که بتوانند تعادل باکتریایی واژن را بازگردانند. خوددرمانی در این ناحیه بسیار خطرناک است زیرا مصرف داروی اشتباه میتواند عفونت را مزمن کرده و به لولههای رحمی آسیب برساند.
پزشکان متخصص زنان معمولاً پس از معاینه و اطمینان از باکتریایی بودن ترشحات، قوی ترین قرص چرک خشک کن برای عفونت واژن را که کمترین عارضه را برای سیستم تناسلی داشته باشد، تجویز میکنند. این داروها گاهی به صورت خوراکی و گاهی به صورت ژل یا کرم واژینال استفاده میشوند تا اثرگذاری موضعی بیشتری داشته باشند.
داروهای موثر برای عفونتهای باکتریایی و انگلی واژن:
- مترونیدازول (Metronidazole): خط اول درمان برای واژینوز باکتریایی و تریکوموناس.
- کلیندامایسین (Clindamycin): گزینهای قوی برای عفونتهای مقاوم یا در دوران بارداری (با تجویز پزشک).
- تینیدازول (Tinidazole): مشابه مترونیدازول اما با طول دوره درمان کوتاهتر.
- آزیترومایسین: در موارد خاص برای عفونتهای مقاربتی مثل کلامیدیا.
قوی ترین قرص آنتی بیوتیک برای عفونت گلو
گلودرد یکی از شایعترین شکایات پزشکی است، اما جالب است بدانید که اکثر گلودردها ویروسی هستند و اصلاً به چرک خشک کن نیاز ندارند. با این حال، اگر آزمایش کشت گلو وجود باکتری “استرپتوکوک” را تأیید کند، پزشک به سراغ تجویز قوی ترین قرص آنتی بیوتیک برای عفونت گلو متناسب با سن و وزن بیمار میرود. هدف از تجویز این داروها، پیشگیری از عوارض جدی مانند تب روماتیسمی یا آسیب به دریچههای قلبی است.
در مواردی که عفونت گلو بسیار شدید باشد یا بیمار به پنیسیلین حساسیت داشته باشد، پزشک گزینههای جایگزین را به عنوان قوی ترین قرص آنتی بیوتیک برای عفونت گلو در نظر میگیرد. تکمیل دوره درمان در عفونتهای گلو بسیار حیاتی است، حتی اگر درد و تب پس از دو روز فروکش کند.
قرص چرک خشک کن های رایج و موثر برای عفونت گلو (استرپتوکوکی):
- پنیسیلین (تزریقی یا خوراکی): همچنان طلاییترین استاندارد درمان.
- آموکسیسیلین: رایجترین گزینه خوراکی با تحمل گوارشی خوب.
- آزیترومایسین: انتخابی قوی برای افراد حساس به پنیسیلین.
- کلاریترومایسین: گزینه جایگزین برای عفونتهای مقاومتر.
قوی ترین قرص آنتی آنتی بیوتیک برای عفونت
عبارت قوی ترین قرص آنتی آنتی بیوتیک برای عفونت (یا همان چرک خشک کن) سوالی است که پاسخ واحدی ندارد، زیرا “قویترین” بودن بستگی به این دارد که عفونت در کجای بدن است (ریه، ادرار، پوست یا دندان) و باکتری تا چه حد سرسخت است. با این حال، در پزشکی عمومی، داروهایی که “طیف اثر وسیع” دارند و میتوانند همزمان چندین نوع باکتری را نابود کنند، به عنوان داروهای قدرتمند شناخته میشوند.
استفاده از قوی ترین کپسول چرک خشک کن برای عفونت های ساده، اشتباهی بزرگ است که منجر به ظهور “اَبَرمیکروبها” میشود. پزشکان معمولاً این داروها را برای شرایطی نگه میدارند که عفونت به بافتهای عمیق نفوذ کرده یا بیمار دچار تب بالا و علائم سیستمیک شده است.
داروهای طیف گسترده و قوی برای عفونتهای عمومی و پیچیده:
- کو-آموکسیکلاو (Co-amoxiclav): ترکیبی قدرتمند برای عفونتهای سینوسی، گوش و ریه.
- سیپروفلوکساسین (Ciprofloxacin): بسیار موثر بر عفونتهای ادراری و گوارشی شدید.
- لووفلوکساسین (Levofloxacin): کاربردی در ذاتالریه و عفونتهای مقاوم.
- داکسیسایکلین: موثر بر عفونتهای خاص پوستی و تنفسی.

آنتی بیوتیک برای عفونت بدن
وقتی صحبت از آنتی بیوتیک برای عفونت بدن میشود، منظور عفونتهایی است که احتمال ورود باکتری به جریان خون یا درگیری چندین ارگان وجود دارد. مکانیسم اثر این داروها بسیار شگفتانگیز است؛ آنها پس از جذب در خون، مانند سربازان هوشمند در سراسر بدن به گردش در میآیند و دقیقاً به نقاطی که باکتریها در حال تکثیر هستند حمله میکنند. این داروها یا دیواره محافظ باکتری را سوراخ میکنند (باکتریکش) و یا موتور تولید پروتئین آنها را از کار میاندازند (باکتریواستاتیک).
مصرف صحیح قرص چرک خشک کن برای عفونت بدن باعث میشود تا بار میکروبی خون به سرعت کاهش یابد و سیستم ایمنی بدن فرصت بازسازی پیدا کند. اگر این داروها سر ساعت مصرف نشوند، سطح دارو در خون پایین میآید و باکتریهای نیمهجان دوباره جان میگیرند و حمله را آغاز میکنند.
نحوه تاثیرگذاری و عملکرد بر بدن:
- تخریب دیواره سلولی: باعث ترکیدن باکتریها میشود (مثل پنیسیلینها).
- توقف تولید پروتئین: باکتری را از رشد و تکثیر باز میدارد (مثل تتراسایکلینها).
- تخریب DNA باکتری: جلوگیری از کپیبرداری و زاد و ولد باکتری (مثل فلوروکینولونها).
- پاکسازی سیستمیک: کمک به گلبولهای سفید برای حذف سریعتر لاشه میکروبها از خون.
The Cochrane Collaboration (مرکز کاکرین) درباره نتایج تحقیقات خود در مورد بهینهسازی تجویز آنتیبیوتیک در مراکز درمانی چنین بیان می کند:
پیروی دقیق از راهنمای مصرف: دادهشدن داروی مناسب، با دوز مناسب، به مدت مناسب» باعث کاهش مقاومت باکتریها و افزایش اثربخشی درمان میشود.
چرک خشک کن دندان
درد دندان یکی از طاقتفرساترین تجربههاست و اغلب افراد در این شرایط به دنبال یک چرک خشک کن دندان یا همان آنتیبیوتیک میگردند تا التهاب و عفونت ریشه دندان را کنترل کنند. باید بدانید که آنتیبیوتیکها دندان را درمان نمیکنند (یعنی پوسیدگی را از بین نمیبرند)، بلکه فقط باکتریهای اطراف ریشه و لثه را که باعث آبسه و تورم شدهاند، موقتاً سرکوب میکنند تا دندانپزشک بتواند درمان اصلی (عصبکشی یا کشیدن) را انجام دهد. انتخاب نوع دارو به شدت عفونت بستگی دارد.
در مواردی که عفونت بسیار شدید است و با تورم صورت یا تب همراه میشود، دندانپزشک ممکن است یک چرک خشک کن قوی برای دندان تجویز کند. معمولاً ترکیب دو نوع آنتیبیوتیک برای پوشش دادن طیف وسیعتری از باکتریهای هوازی و بیهوازی استفاده میشود. مصرف خودسرانه این داروها بدون تخلیه عفونت توسط دندانپزشک، فقط باعث پنهان شدن علائم و پیچیدهتر شدن وضعیت در آینده میشود.
داروهای رایج و موثر برای عفونت دندان (با تجویز دندانپزشک):
- آموکسیسیلین (Amoxicillin): رایجترین انتخاب خط اول برای آبسههای دندانی ساده.
- مترونیدازول (Metronidazole): معمولاً به عنوان مکمل در کنار آموکسیسیلین برای مبارزه با باکتریهای بیهوازی تجویز میشود.
- کلیندامایسین (Clindamycin): گزینهای عالی و نفوذکننده به استخوان برای افرادی که به پنیسیلین آلرژی دارند.
- کو-آموکسیکلاو: یک گزینه قدرتمند برای عفونتهای مقاومتر.

بهترین آنتی بیوتیک برای عفونت لثه
عفونت لثه (پریودنتیت یا ژنژیویت) ماهیتی متفاوت با عفونت دندان دارد و معمولاً ناشی از تجمع پلاک و باکتریهای خاصی در پاکتهای لثهای است. برای انتخاب بهترین آنتی بیوتیک برای عفونت لثه، دندانپزشک به دنبال دارویی است که بتواند به خوبی در مایع شیار لثه نفوذ کرده و باکتریهای بیهوازی که عامل اصلی بوی بد و خونریزی هستند را هدف قرار دهد. در بسیاری از موارد، جرمگیری عمیق در کنار مصرف دارو ضروری است.
در مواردی که بیماری لثه پیشرفته باشد و خطر تحلیل استخوان وجود داشته باشد، بهترین کپسول چرک خشک کن برای عفونت لثه میتواند ترکیبی از داروها یا حتی آنتیبیوتیکهای موضعی (مانند ژل یا فیبرهای قرار داده شده در زیر لثه) باشد. این داروها کمک میکنند تا باکتریهای مخرب از بین بروند و لثه فرصت ترمیم پیدا کند، اما بدون رعایت بهداشت دهان، اثر آنها موقتی خواهد بود.
آنتیبیوتیکهای تخصصی برای بیماریهای لثه:
- مترونیدازول: بسیار موثر بر باکتریهای بیهوازی که عامل اصلی عفونت لثه هستند.
- تتراسایکلین / داکسیسایکلین: علاوه بر خاصیت ضد میکروبی، خاصیت ضد التهابی دارند و از تخریب کلاژن لثه جلوگیری میکنند.
- آزیترومایسین: در برخی انواع خاص بیماریهای لثه که با رشد زیاد بافت همراه است، موثر میباشد.
- سیپروفلوکساسین: گاهی برای انواع خاصی از باکتریهای لثه تجویز میشود.
بهترین آنتی بیوتیک برای عفونت لثه کودکان
سیستم ایمنی و ساختار دندانی کودکان بسیار حساس است و انتخاب بهترین آنتی بیوتیک برای عفونت لثه کودکان نیازمند دقت فراوانی است. برخی داروها مانند تتراسایکلینها برای کودکان زیر ۸ سال ممنوع هستند، زیرا میتوانند باعث تغییر رنگ دائمی دندانهای دائمی در حال رشد شوند. بنابراین، دندانپزشک اطفال معمولاً از داروهای ایمنتر با طعم بهتر (شربت یا سوسپانسیون) استفاده میکند تا کودک در مصرف آن همکاری کند.
والدین باید توجه داشته باشند که تورم یا قرمزی لثه کودک همیشه نیاز به چرک خشک کن ندارد و گاهی ناشی از رویش دندان یا عفونتهای ویروسی است. اما اگر عفونت باکتریایی تایید شود، مصرف دقیق دارو طبق ساعت و دوز تعیین شده بر اساس وزن کودک، برای جلوگیری از آسیب به جوانههای دندان دائمی ضروری است.
گزینههای ایمن برای کودکان (تحت نظر متخصص اطفال):
- شربت آموکسیسیلین: ایمنترین و رایجترین گزینه برای اطفال به همراه شربت مترونیدازول برای کودکان است.
- شربت کو-آموکسیکلاو: برای عفونتهای شدیدتر که به آموکسیسیلین پاسخ ندادهاند.
- آزیترومایسین (سوسپانسیون): جایگزین مناسب برای کودکانی که به پنیسیلین حساسیت دارند.
- کلیندامایسین (مایع): برای عفونتهای جدی استخوان فک و لثه در کودکان.
آنتی بیوتیک برای عفونت سقف دهان
عفونت سقف دهان (کام) میتواند بسیار دردناک باشد و غذا خوردن را مختل کند. این عفونت معمولاً ناشی از گسترش آبسه ریشه دندانهای فک بالا به سمت کام یا آسیبهای فیزیکی است. پزشک برای تجویز چرک خشک کن برای عفونت سقف دهان، ابتدا باید مطمئن شود که عامل عفونت باکتری است؛ چرا که گاهی عفونتهای قارچی (کاندیدیازیس) یا سوختگی با غذای داغ علائم مشابهی ایجاد میکنند که با آنتیبیوتیک درمان نمیشوند.
اگر منشأ مشکل، آبسه دندانی باشد که به سقف دهان راه باز کرده، استفاده از آنتی بیوتیک برای عفونت سقف دهان به کاهش فشار و جلوگیری از ورود عفونت به سینوسها کمک میکند. در این ناحیه به دلیل بافت سخت و مخاطی، نفوذ دارو اهمیت دارد و معمولاً داروهای با جذب بالا تجویز میشوند تا به سرعت التهاب را کاهش دهند.
داروهای موثر برای آبسههای کامی و سقف دهان:
- آموکسیسیلین: برای کنترل عفونتهای باکتریایی عمومی در ناحیه کام.
- سفالکسین: در صورت وجود عفونتهای بافت نرم و سلولیت سقف دهان.
- کلیندامایسین: به دلیل نفوذ عالی در بافت استخوانی فک بالا و کام.
- پنیسیلین V: فرم خوراکی پنیسیلین برای عفونتهای خفیف تا متوسط.

آنتی بیوتیک برای بوی بد دهان
بسیاری از افراد تصور میکنند که بوی بد دهان (هالیتوزیس) را میتوان با مصرف دارو برطرف کرد و در اینترنت به دنبال آنتی بیوتیک برای بوی بد دهان میگردند. واقعیت این است که بوی بد دهان اغلب ناشی از فعالیت باکتریهای تولیدکننده گوگرد روی زبان یا لثه است. اگرچه آنتیبیوتیکها میتوانند این باکتریها را موقتاً کاهش دهند، اما به محض قطع دارو، اگر علت اصلی (مثل جرم دندان، پوسیدگی یا سنگ لوزه) برطرف نشود، بوی بد با شدت بیشتری باز میگردد.
با این حال، در موارد خاصی که بوی بد ناشی از عفونت حاد لثه (مانند ANUG) یا عفونت سینوسها باشد، پزشک ممکن است یک دوره کوتاه چرک خشک کن برای بوی بد دهان تجویز کند. استفاده طولانیمدت از آنتیبیوتیک برای رفع بوی دهان اشتباهی بزرگ است که باعث مقاوم شدن باکتریها و از بین رفتن فلور مفید دهان میشود.
داروهایی که ممکن است بر بوی بد ناشی از عفونت اثر بگذارند:
- مترونیدازول: موثرترین دارو بر باکتریهای بیهوازی تولیدکننده بوی بد (فقط برای درمان عفونت، نه خوشبو کردن).
- آموکسیسیلین: اگر بوی بد ناشی از عفونت سینوزیت یا لوزهها باشد.
- داکسیسایکلین: در موارد بیماریهای پیشرفته پریودنتال که باعث بوی نامطبوع میشوند.
- دهانشویه کلرهگزیدین: (آنتیبیوتیک نیست اما ضدعفونیکننده قوی است) اغلب به جای قرص برای کاهش بار میکروبی و بوی دهان تجویز میشود.
انواع آنتی بیوتیک ها برای سرماخوردگی
یکی از رایجترین اشتباهات پزشکی که بسیاری از افراد مرتکب میشوند، جستجو برای یافتن انواع آنتی بیوتیک ها برای سرماخوردگی است. باید با صراحت علمی بگوییم که سرماخوردگی و آنفولانزا بیماریهایی با منشأ “ویروسی” هستند، در حالی که آنتیبیوتیکها صرفاً برای کشتن “باکتریها” طراحی شدهاند. بنابراین، مصرف قویترین چرک خشک کنها نیز هیچ تأثیری بر درمان ویروس سرماخوردگی ندارد و نه تنها دوره بیماری را کوتاه نمیکند، بلکه با نابودی باکتریهای مفید بدن، سیستم ایمنی شما را ضعیفتر کرده و زمینه را برای بیماریهای بعدی فراهم میکند.
با این حال، گاهی اوقات پزشک در جریان یک سرماخوردگی طولانیمدت، اقدام به تجویز انواع چرک خشک کن ها برای سرماخوردگی میکند. این اتفاق تنها زمانی رخ میدهد که عفونت ویروسی اولیه، زمینهساز بروز یک “عفونت ثانویه باکتریایی” شده باشد؛ مثلاً سرماخوردگی منجر به عفونت شدید سینوسها (سینوزیت باکتریایی)، عفونت گوش میانی یا برونشیت شده باشد. در این شرایط خاص، داروی تجویز شده برای درمان عوارض است، نه خود ویروس سرماخوردگی.
آنتیبیوتیکهایی که صرفاً در صورت بروز عوارض باکتریایی (نه برای خود سرماخوردگی) تجویز میشوند:
- آزیترومایسین: معمولاً برای عفونتهای باکتریایی تنفسی یا گوش که پس از سرماخوردگی عود میکنند.
- کو-آموکسیکلاو: برای سینوزیتهای چرکی و مقاوم که بیش از ۱۰ روز طول کشیده باشند.
- لووفلوکساسین: برای عفونتهای ریوی شدید (مانند ذاتالریه) در بزرگسالان.
- سفیکسیم: گاهی برای جلوگیری از گسترش عفونتهای تنفسی ثانویه در افراد پرخطر.
عکس قرص آنتی بیوتیک
مشاهده عکس قرص آنتی بیوتیک میتواند به بیماران کمک کند تا داروی تجویز شده توسط پزشک را بهتر بشناسند و از اشتباهات دارویی جلوگیری کنند. آنتیبیوتیکها در اشکال و رنگهای بسیار متنوعی تولید میشوند؛ از کپسولهای دو رنگ معروف گرفته تا قرصهای سفید بزرگ و شربتهای سوسپانسیون کودکان. نکته مهمی که با دیدن تصویر قرص آنتی بیوتیک باید به یاد داشته باشید این است که هرگز نباید قدرت یا نوع دارو را از روی ظاهر آن قضاوت کنید؛ زیرا بسیاری از داروها ظاهری مشابه دارند اما عملکردی کاملاً متفاوت و حتی متضاد در بدن ایفا میکنند و حتماً باید نام درج شده روی ورق دارو (بلیستر) چک شود.

نتیجه گیری
در پایان، باید پذیرفت که آنتی بیوتیک یا همان کپسول چرک خشک کن، شمشیر دو لبهای است که اگر درست استفاده شود، نجاتبخش جان انسانهاست و اگر نابجا مصرف گردد، میتواند سلامت فرد و جامعه را با ایجاد باکتریهای مقاوم تهدید کند. دانستیم که هر عفونتی نیاز به این داروها ندارد و تشخیص مرز بین بیماری ویروسی و باکتریایی تنها در صلاحیت پزشک است. مسئولیت ما در قبال سلامتیمان این است که دوره درمان را کامل کنیم، از خوددرمانی بپرهیزیم و اجازه دهیم سیستم دفاعی بدن در موارد غیرضروری، خود سکان هدایت را به دست بگیرد.
گاهی اوقات عفونتها در نواحی حساس و خاصی از بدن مانند ناحیه مقعدی بروز میکنند که نیازمند توجه ویژهای هستند. آبسههای مقعدی یا فیستولها نمونههایی از این عفونتها هستند که اغلب با دارو به تنهایی درمان نمیشوند. در این راستا، کلینیک پارادایس به عنوان مرکز تخصصی درمان بیماریهای نشیمنگاهی، با بهرهگیری از تکنولوژیهای روز و روشهای نوین لیزری، فضایی امن و حرفهای را برای تشخیص و درمان قطعی این عارضهها فراهم کرده است تا بیماران بدون نگرانی از عود عفونت، سلامتی کامل خود را بازیابند.
سوالات متداول (FAQ)
آیا مصرف شیر یا لبنیات اثر آنتی بیوتیکها را از بین میبرد؟
در مورد برخی گروههای دارویی بله. کلسیم موجود در لبنیات میتواند به داروهایی مانند تتراسایکلینها، داکسیسایکلین و سیپروفلوکساسین متصل شده و مانع جذب آنها شود. بهتر است این داروها را ۱ تا ۲ ساعت قبل یا بعد از لبنیات مصرف کنید.
اگر یک نوبت مصرف دارو را فراموش کردیم، چه باید کرد؟
اگر زمان زیادی تا نوبت بعدی باقی مانده، بلافاصله دارو را مصرف کنید. اما اگر نزدیک به نوبت بعدی هستید، دوز فراموش شده را رها کنید و نوبت بعدی را سر ساعت بخورید. هرگز برای جبران، دو قرص را همزمان نخورید.
چرا پس از مصرف آنتیبیوتیک دچار اسهال میشویم و درمان آن چیست؟
آنتیبیوتیکها باکتریهای مفید روده را نیز از بین میبرند که منجر به عدم تعادل گوارشی میشود. مصرف مکملهای “پروبیوتیک” یا ماستهای حاوی پروبیوتیک در طول دوره درمان و پس از آن، به بازسازی فلور روده و کاهش این عارضه کمک شایانی میکند.
آیا تزریق آمپول پنیسیلین برای هر گلودردی لازم است؟
خیر. اکثر گلودردها ویروسی هستند و پنیسیلین روی آنها اثری ندارد. تزریق پنیسیلین تنها زمانی توصیه میشود که تست استرپتوکوکی گلو مثبت باشد یا پزشک علائم قطعی عفونت باکتریایی را مشاهده کند تا از عوارضی مثل تب روماتیسمی جلوگیری شود.